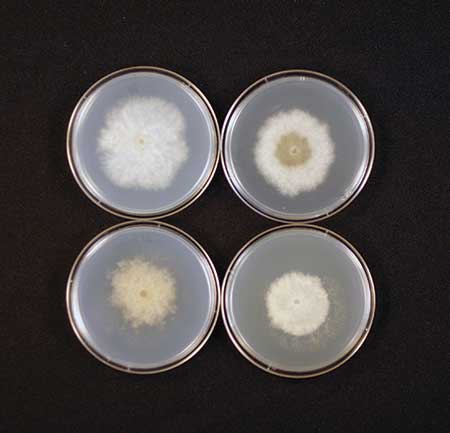

Understanding fungicide resistance

As increasing amounts of fungicide are applied, the sensitive population (top row) decreases while the resistant population persists. (Photo: Rick Latin)
Everyone engaged in establishing and maintaining healthy turf should be familiar with fungicide resistance. It occurs when a once-effective active ingredient is no longer able to stop pathogen growth and control disease (Figure 1).
The phrase “once-effective” is essential to understanding fungicide resistance. It implies that something has changed in the pathogen to reduce the efficacy of a fungicide. The change is genetic, meaning the resistance trait can be passed on to future pathogen generations.
Pathogen strains that are not resistant are said to be sensitive — i.e., sensitive to a fungicide’s toxic effect. Although the term “insensitive” is sometimes used to describe fungicide resistance, the term “resistant” is used here with the understanding that there are different degrees of resistance depending on the pathogen and fungicide.
This narrative provides an overview of fungicide resistance, addressing the fundamental elements and practical consequences of fungicide resistance as it relates to turf disease control.
It’s chemical and biological
Fungicide resistance has chemical and biological components. The chemical component is defined by the pathogen- inhibiting nature of a fungicide active ingredient. Fungicides are classified as having multisite inhibitors or single-site — site-specific — inhibitors.
Fungicides with multisite inhibitors tend to be among the older compounds but can be very effective. Chlorothalonil is one of the most valuable multisite fungicides. Once inside a fungal cell, chlorothalonil targets groups of atoms — called thiol functional groups — common components of many essential proteins. Such proteins regulate thousands of metabolic functions required for fungal growth. To overcome the effects of chlorothalonil, thousands of simultaneous changes in fungal protein chemistry would need to occur without interrupting other life functions of the pathogen. The likelihood of that scenario is zero or nearly as close to zero as biologically possible.
Almost all of the modern fungicides are single-site inhibitors — i.e., they disturb only a single metabolic function in the target pathogen. For example, DMI fungicides disrupt the biosynthesis of a single compound called ergosterol, an essential component of cell membranes in pathogenic fungi. Without ample supplies of ergosterol, fungal growth will stop because of cell membrane failure, and turf will recover. Changes in a pathogen’s genetic makeup to overcome a fungicide’s inhibitory effect on ergosterol biosynthesis will allow fungal growth to continue, rendering DMI active ingredients less effective or ineffective. The likelihood that a single metabolic change will naturally appear in a population is reasonably high.
The biological component of resistance relates to pathogen populations. Resistance issues are most likely to occur in pathogens that produce vast populations. To date, fungicide resistance has been identified in pathogens responsible for dollar spot, anthracnose, gray leaf spot, Microdochium patch and Pythium blight.
The dollar spot pathogen, Sclerotinia homoeocarpa, is active during the entire season in the Northeast. Colletotrichum cereale, the anthracnose pathogen, also will infect over a broad temperature range, and just one infected plant can produce hundreds of thousands of infectious spores. Vast numbers of aerial disseminated Pyricularia grisea spores are produced within individual gray leaf spot lesions. The Microdochium patch pathogen, Microdochium nivale, is another efficient spore-producer active in the Pacific Northwest for nine or more months every year.
Finally, under ideal environmental conditions, the Pythium spp. spores are quick to infect, have a short generation time and can create an abundance of spores during a 12-hour period. The only common characteristic of these pathogens is that they produce massive populations.
Several turf pathogens are capable of producing large populations, but not all are equally likely to develop fungicide resistance. Table 1 shows the biological and chemical combinations with confirmed cases of fungicide resistance. All of the pathogens listed in Table 1 generate massive populations of infectious cells, and all of the active ingredients are single-site inhibitors. As new active ingredients are introduced, we must remain cognizant that all single-site fungicides are vulnerable to the evolution of pathogen resistance, especially in the five previously discussed pathogens.
This is important because SDHI compounds target two of the most notorious pathogens on the list of pathogens with known resistance issues: S. homoeocarpa and C. cereale.
Applying different fungicides from the same class will not control a cross-resistant pathogen population. (Photo: Rick Latin)
Resistance expression can be classified as qualitative or quantitative. Qualitative expression means that a pathogen population is comprised of two types, totally resistant and totally sensitive.
Quantitative expression indicates that a pathogen population is comprised of numerous types with various levels of fungicide sensitivity. Interpreting qualitative and quantitative expression is important from a practical standpoint.
In the field, quantitative expression — e.g., dollar spot resistance to DMI fungicides — is characterized by a gradual erosion of sensitivity. A fungicide does not completely lose its ability to control a pathogen, and, in some cases, satisfactory levels of control can be achieved with higher application rates or shorter intervals. Qualitative expression is characteristic of benzimidazole — e.g., thiophanate-methyl — resistance in dollar spot populations.
Where dollar spot is predominantly benzimidazole-resistant, increasing the product application rate or shortening the application interval of benzimidazole will not result in control.
Cross and multiple resistance
The term “mode of action” is often used when discussing fungicides. Mode of action refers to the interaction between a fungicide and a pathogen. Fungicides with the same mode of action disturb the same metabolic function in pathogens.
For example, all DMI fungicides have the same mode of action — i.e., they all interfere with ergosterol biosynthesis in the same manner. The DMI class of fungicides includes metconazole, myclobutanil, propiconazole, tebuconazole, triadimefon and triticonazole. Mode of action is an important consideration because when a pathogen develops resistance to one active ingredient in a class of fungicides, it should be expected that it will also develop resistance to the other active ingredients in that class. Resistance within a fungicide class is referred to as cross resistance (Figure 2). It cannot be emphasized enough — pathogen populations that develop resistance to one active ingredient have the potential to develop resistance to all other active ingredients within that class of fungicides.
When active ingredients from two or more fungicide classes with single-sit inhibitors are used to control a disease, resistance to more than one class of fungicide — i.e., multiple resistance — can occur. All living things have an inherent natural tendency to change or adapt in the presence of existential threats in order to survive.
Where single-site fungicides from different classes have been used against crop pathogens, resistance to multiple fungicide classes has developed.
As presented in Table 2, observations of multiple resistance have been reported for several pathogens. The issue with multiple resistance is not if it will occur, rather how quickly and what can be done to delay its development.
Evolution of resistance
A mutation is the first step in developing fungicide resistance. Current scientific thinking holds that the appearance of a fungicide-resistant individual in a population is a natural but rare phenomenon.
Since mutation is rare, the likelihood that a resistant individual will appear is a function of population size. With regard to turf disease control, implementing a preventive management strategy to keep pathogen populations low lessens the chance that a resistant strain will materialize. Odds of developing a fungicide-resistant strain will increase if large populations of pathogen are allowed to develop. Only applying fungicides in a curative fashion without any preventive management may allow large populations to develop, increasing the risk of resistance.
The first step toward resistance — i.e., a mutation — is likely a natural occurrence. The second step, however, is a human action. One fungicide-resistant pathogen cell will not cause a problem on its own. The situation becomes problematic only when a resistant individual reproduces, causing a pathogen population to shift toward fungicide resistance as resistant offspring proliferate. Ultimately, the evolution of fungicide-resistant populations is a function of selection pressure. In the world of fungicide resistance, selection pressure increases when fungicides from the same class are repeatedly applied.
When a fungicide is applied to a pathogen population with resistant individuals, the sensitive strains are neutralized, but the resistant strains are still able to grow (Figure 3). Therefore, applying the fungicide provides a competitive advantage to the resistant strain, eventually allowing it to become predominant in the population. As a result, the efficacy of that fungicide — or fungicide class — will decrease. The dose and frequency of fungicide applications influences the rate at which a pathogen population may evolve into one that is predominantly resistant. Higher doses and more frequent applications hasten the evolution toward resistance. There should be no question that the quickest way to develop a fungicide-resistant population is to exclusively apply fungicides within the same class.
A practical approach
Eventually, a comprehensive understanding of resistance mechanisms will guide the use of fungicides for turf disease control. Until then, disease control should be based on a simple strategy to manage the two-step process that drives the evolution of resistance. Since mutations toward fungicide resistance are more likely to occur in large populations, tactics designed to keep pathogen populations low can help avoid resistance.
Exercise all nonchemical options to control fungal populations. Preventive disease control is encouraged, especially programs that do not involve fungicides with single-site inhibitors. Fungicides with multisite inhibitors are also important tools because they decrease the likelihood of resistant pathogen populations.
Limiting the use of single-site compounds, or tank mixing them with multisite products, will greatly reduce the rate at which resistance develops.
Finally, and most importantly, avoid the exclusive use of one fungicide class to control a disease. Rotating among different fungicide classes remains one of the best techniques to avoid fungicide resistance.
Editor’s Note: For the complete version of this article, visit the USGA website on turfgrass disease management. This article is reprinted from the July 2017 Vol. 55 (13) of the USGA Green Section Record. Copyright United States Golf Association. All Rights Reserved.














